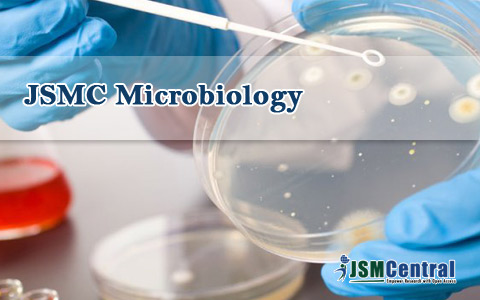

Journals
-

SM Journal of Infectious Diseases
Discipline | Clinical Medicine
Publisher, JSMCentralHost Invasions | Infectious Agents | Disease Control
SM Journal of Infectious Diseases is an open access peer reviewed journal publishing articles those investigate antibiotic and antifungal drug development, bacterial pathogenesis and drug resist...Readmore
ISSN: 3066-134X Archive Submit a Manuscript Editors -

SM Journal of Medicinal Plant Studies
Discipline | Life Sciences Group
Publisher, JSMCentralEthnobotany | Traditional Medicine | Active Phytochemicals
SM Journal of Medicinal Plant Studies is an open access peer reviewed journal publishing articles those focus on molecular biology/biotechnology, medicinal plant breeding and genetic improvement...Readmore
ISSN: 2638-4698 Archive Submit a Manuscript Editors -

SM Journal of Arthritis Research
Discipline | Clinical Medicine
Publisher, JSMCentralRheumatic Disease | Osteoarthritis | Joint Inflammation
SM Journal of Arthritis Research is an open access peer reviewed journal publishing articles focused in Rheumatic diseases affect joints tendons, ligaments, bones, and muscles. Our experienced t...Readmore
ISSN: 2637-8841 Archive Submit a Manuscript Editors -

SM Journal of Clinical Anatomy
Discipline | Clinical Medicine
Publisher, JSMCentralGross Anatomy | Microscopic Anatomy | Macroscopic Anatomy
SM Journal of Clinical Anatomy is an open access peer reviewed journal publishing articles focused on research in Molecular, Cellular & Developmental Biology, Neuroscience, and Evolutionary ...Readmore
ISSN: 2578-6954 Archive Submit a Manuscript Editors -

SM Journal of Sleep Disorders
Discipline | Clinical Medicine
Publisher, JSMCentralInsomnia | Sleep Apnea | Sleep Problems
SM Journal of Sleep Disorders is an open access peer reviewed journal publishing articles committed to provide significant information on Insomnia, Sleep Apnea, Parasomnias, Restless Leg Syndrom...Readmore
ISSN: 2576-5485 Archive Submit a Manuscript Editors -

SM Journal of Psychiatry & Mental Health
Discipline | Clinical Medicine
Publisher, JSMCentralMental Disorders | Depressive Disorder | Psychiatric Rehabiliation
SM Journal of Psychiatry & Mental Health is an open access peer reviewed journal publishing articles focused on major psychiatric disorders and mental wellbeing, etc. Our experienced team of...Readmore
ISSN: 2576-5477 Archive Submit a Manuscript Editors -

SM Journal of Nephrology and Kidney Diseases
Discipline | Clinical Medicine
Publisher, JSMCentralKidney Surgery | Dialysis | Kidney Cancers
SM Journal of Nephrology and Kidney Diseases is an open access peer reviewed journal publishing articles those focus on hereditary kidney diseases, nephrolithiasis, pharmacogenetics, end-stage r...Readmore
ISSN: 2576-5450 Archive Submit a Manuscript Editors -

SM Musculoskeletal Disorders
Discipline | Clinical Medicine
Publisher, JSMCentralRheumatology | Orthopedic Trauma | Musculoskeletal Problems
SM Musculoskeletal Disorders is an open access peer reviewed journal publishing articles including areas of CT, MRI, arthrography, musculoskeletal ultrasound, bone biopsies and bone mineral dens...Readmore
ISSN: 2576-5442 Archive Submit a Manuscript Editors -

SM Gerontology and Geriatric Research
Discipline | Clinical Medicine
Publisher, JSMCentralGeriatric Health | Geriatric Diseases | Geriatric Nursing
SM Gerontology and Geriatric Research Journal is an open access peer reviewed journal publishing articles covering the multidisciplinary study of physical, social, and psychological aspects of a...Readmore
ISSN: 2576-5434 Archive Submit a Manuscript Editors -

Annals of Applied Microbiology & Biotechnology Journal
Discipline | Life Sciences Group
Publisher, JSMCentralMicrobiology, Biotechnology, Applied Sciences
Annals of Applied Microbiology & Biotechnology Journal is an international, open access peer reviewed journal publishing high quality articles in the contributions to the na...Readmore
ISSN: 2576-5426 Archive Submit a Manuscript Editors -

SM Preventive Medicine and Public Health
Discipline | Clinical Medicine
Publisher, JSMCentralCancer Prevention | Diabetes Prevention | Heart Health
SM Preventive Medicine and Public Health journal is an open access peer reviewed journal publishing articles in broad research portfolio to investigate addiction, cancer, diabetes, environmental...Readmore
ISSN: 2576-4004 Archive Submit a Manuscript Editors -

SM Emergency Medicine and Critical Care
Discipline | Clinical Medicine
Publisher, JSMCentralIntensive Care | Trauma Management | Life Support
SM Emergency Medicine and Critical Care Journal is an open access peer reviewed journal publishing articles committed to providing patients seeking emergency care with time sensitive interventio...Readmore
ISSN: 2576-0173 Archive Submit a Manuscript Editors -

International Journal of Animal Science
Discipline | Clinical Medicine
Publisher, JSMCentralVeterinary Sciences | Veterinary Surgeries | Veterinary Pathology
International Journal of Animal Science is an open access peer reviewed journal publishing articles and its dissemination, and implementation of scientific knowledge to improve the health and we...Readmore
ISSN: 2575-7806 Archive Submit a Manuscript Editors -

SM Dermatology Journal
Discipline | Clinical Medicine
Publisher, JSMCentralSkin Diseases | Dermatological Cancers | Dermatological Surgeries
SM Dermatology Journal is an open access peer reviewed journal publishing articles in areas including but not limiting to diagnosis and treatment of Skin Cancers, Pigmented Lesions and Melanoma,...Readmore
ISSN: 2575-7792 Archive Submit a Manuscript Editors -

SM Dentistry Journal
Discipline | Clinical Medicine
Publisher, JSMCentralDental Surgery | Pediatric Dentistry | Oral Health
SM Dentistry Journal is an open access peer reviewed journal publishing articles in areas including Basic Science & Craniofacial Biology, Biomaterials, Cariology & Comprehensive Care, En...Readmore
ISSN: 2575-7776 Archive Submit a Manuscript Editors -

SM Journal of Urology
Discipline | Clinical Medicine
Publisher, JSMCentralUrogynecology | Endoscopic Urology | Urological Surgeries
SM Journal of Urology is an open access peer reviewed journal publishing articles committed to provide significant information on Pediatric Urology, Urologic Oncology, Renal Transplant, Male Inf...Readmore
ISSN: 2574-8017 Archive Submit a Manuscript Editors -

SM Journal of Forensic Research and Criminology
Discipline | Life Sciences Group
Publisher, JSMCentralMurder Analysis | Crime Scene | Forensic Pathology
SM Journal of Forensic Research and Criminology is an open access peer reviewed journal publishing articles that focus on disciplines include forensic molecular biology (DNA), forensic chemistry...Readmore
ISSN: 2574-2426 Archive Submit a Manuscript Editors -

SM Otolaryngology
Discipline | Clinical Medicine
Publisher, JSMCentralNeuro-otology | Larynx Disorders | Pharynx Disorders
SM Otolaryngology journal is an open access peer reviewed journal publishing articles including areas of Audiology, Facial Plastic and Reconstructive Surgery, Otology & Neurotology, Sinus, T...Readmore
ISSN: 2574-2418 Archive Submit a Manuscript Editors -

SM Journal of Pulmonary Medicine
Discipline | Clinical Medicine
Publisher, JSMCentralLung Cancers | Respiratory Medicine | Lung Surgery
SM Journal of Pulmonary Medicine is an open access peer reviewed journal publishing articles committed to provide significant information on allergy, pulmonary hypertension, lung transplant, cri...Readmore
ISSN: 2574-240X Archive Submit a Manuscript Editors -

SM Journal of Pharmacology and Therapeutics
Discipline | Chemistry
Publisher, JSMCentralDrug Development | Drug Targets | Drug Effects
SM Journal of Pharmacology and Therapeutics is an open access peer reviewed journal publishing articles providing information on research, education, identification of new pharmacologic targets ...Readmore
ISSN: 2574-2396 Archive Submit a Manuscript Editors -

SM Journal of Gynecology and Obstetrics
Discipline | Clinical Medicine
Publisher, JSMCentralWomans Health | Gynecological Cancers | Gynecological Surgeries
SM Journal of Gynecology and Obstetrics is an open access peer reviewed journal publishing articles that focus on key functional areas such as Clinical Trials, Endometriosis, Family Planning, Gl...Readmore
ISSN: 2573-6744 Archive Submit a Manuscript Editors -

SM Journal of Neurology and Neuroscience
Discipline | Clinical Medicine
Publisher, JSMCentralBrain Science | Brain Tumors | Neurosurgery
SM Journal of Neurology and Neuroscience is an open access peer reviewed journal publishing articles providing information on epilepsy, movement disorders, dementias and other cognitive conditio...Readmore
ISSN: 2573-6728 Archive Submit a Manuscript Editors -

SM Journal of Biometrics & Biostatistics
Discipline | Life Sciences Group
Publisher, JSMCentralMetric Evaluation | Statistical Analysis | Bioauthentication
SM Journal of Biometrics & Biostatistics is an open access peer reviewed journal publishing articles focused on scientific questions, plan and evaluate study designs, collect and interpret d...Readmore
ISSN: 2573-5470 Archive Submit a Manuscript Editors -

SM Journal of Nutrition and Metabolism
Discipline | Clinical Medicine
Publisher, JSMCentralNutritional Disorders | Metabolism Disorders | Human Nutrition
SM Journal of Nutrition and Metabolism is an open access peer reviewed journal publishing articles providing new information about the relationships between diet, physical activity, health and d...Readmore
ISSN: 2573-5462 Archive Submit a Manuscript Editors -

SM Analytical and Bioanalytical Techniques
Discipline | Chemistry
Publisher, JSMCentralAnalytical Techniques | Bioanalytical Techniques | Analysis
SM Analytical and Bioanalytical Techniques journalis an open access peer reviewed journal publishing articles those promote information about analytical methods used for characterization, releas...Readmore
ISSN: 2573-3729 Archive Submit a Manuscript Editors -

SM Journal of Biology
Discipline | Life Sciences Group
Publisher, JSMCentralCellular Science | Environmental Science | Molecular Interactions
SM Journal of Biology is an open access peer reviewed journal publishing articles focused in key areas of Behavior, Biochemistry, Biophysics, Cell Biology, Computational Biology, Conservation Bi...Readmore
ISSN: 2573-3710 Archive Submit a Manuscript Editors -

SM Journal of Biomedical Engineering
Discipline | Life Sciences Group
Publisher, JSMCentralTissue Engineering| Cell Engineering | Biomaterials
SM Journal of Biomedical Engineering is an open access peer reviewed journal publishing articles focused in key functional areas of Biomechanics and Mechanobiology, Molecular, Cellular, and Tiss...Readmore
ISSN: 2573-3702 Archive Submit a Manuscript Editors -

SM Journal of Clinical Medicine
Discipline | Clinical Medicine
Publisher, JSMCentralGeneral Medicine | Surgery | Imaging
SM Journal of Clinical Medicine is an open access peer reviewed journal publishing articles focused on research in orthopedics, urology, plastic surgery, anesthesiology, pathology, radiology, ne...Readmore
ISSN: 2573-3680 Archive Submit a Manuscript Editors -

SM Journal of Hepatitis Research and Treatment
Discipline | Clinical Medicine
Publisher, JSMCentralFatty Liver | HAV | HBV
SM Journal of Hepatitis Research and Treatment is an open access peer reviewed journal publishing articles that focus on key functional areas such as hepatitis, viral hepatitis, inflammation of ...Readmore
ISSN: 2573-3672 Archive Submit a Manuscript Editors -

SM Journal of Food and Nutritional Disorders
Discipline | Clinical Medicine
Publisher, JSMCentralNutrition | Food Science | Nutraceutics
SM Journal of Food and Nutritional Disorders is an open access peer reviewed journal publishing articles focused in the following signature areas like Metabolism and Obesity, Minerals, Vita...Readmore
ISSN: 2573-3664 Archive Submit a Manuscript Editors -

SM Journal of Community Medicine
Discipline | Clinical Medicine
Publisher, JSMCentralCommunity Health | Public Health | Occupational Health
SM Journal of Community Medicine is an open access peer reviewed journal publishing articles that provides significant information on environmental and occupational health, health inequality and...Readmore
ISSN: 2573-3648 Archive Submit a Manuscript Editors -

SM Tropical Medicine Journal
Discipline | Clinical Medicine
Publisher, JSMCentralPrimary Care | Disease Control | Ambulatory Tropical Medicine
SM Tropical Medicine Journal is an open access peer reviewed journal publishing articles in fields of tropical medicine, parasitology and applied population-based malaria evaluation research, cl...Readmore
ISSN: 2573-363X Archive Submit a Manuscript Editors -

SM Journal of Pediatric Surgery
Discipline | Clinical Medicine
Publisher, JSMCentralSurgery of Fetuses | Surgical Care | Birth Defects
SM Journal of Pediatric Surgery is an open access peer reviewed journal publishing articles providing information on research of pediatric surgeries such as Appendicitis, Biliary atresia, Cancer...Readmore
ISSN: 2573-3419 Archive Submit a Manuscript Editors -

SM Journal of Depression Research and Treatment
Discipline | Clinical Medicine
Publisher, JSMCentralDepressive Disorder | Mental Health | Rehabiliation
SM Journal of Depression Research and Treatment is an open access peer reviewed journal publishing articles that provides significant information on Depression, other mental health disorders, an...Readmore
ISSN: 2573-3389 Archive Submit a Manuscript Editors -

SM Journal of Nursing
Discipline | Clinical Medicine
Publisher, JSMCentralMidwifery | Evidence Based Medicine | Nursing Education
SM Journal of Nursing is an open access peer reviewed journal publishing articles promoting excellence in nursing and health care, etc. Our experienced team of experts provides editorial excelle...Readmore
ISSN: 2573-3249 Archive Submit a Manuscript Editors -

Annals of Chromatography and Separation Techniques
Discipline | Chemistry
Publisher, JSMCentralChromatography | Separation Techniques | Analytical Techniques
Annals of Chromatography and Separation Techniques journal is an open access peer reviewed journal publishing high quality articles in the contributions to various analytical and bioanalytical s...Readmore
ISSN: 2473-0696 Archive Submit a Manuscript Editors -

SM Case Reports
Discipline | Clinical Medicine
Publisher, JSMCentralMedical Cases | Clinical Cases | Health Surveys
SM Journal of Case Reports journal is an open access peer reviewed journal publishing improvements to patient outcomes those result from important studies, investigations, and advances in clinic...Readmore
ISSN: 2473-0688 Archive Submit a Manuscript Editors -

SM Journal of Orthopedics
Discipline | Clinical Medicine
Publisher, JSMCentralOrthopedic Surgery | Orthopedic Treatment | Orthopedic Cancers
SM Journal of Orthopedics is an open access peer reviewed journal publishing articles providing information on carpal tunnel syndrome, peripheral neuropathy, kyphoplasty, neck pain, shoulder pai...Readmore
ISSN: 2473-067X Archive Submit a Manuscript Editors -

SM Journal of Public Health & Epidemiology
Discipline | Clinical Medicine
Publisher, JSMCentralEpidemic Outbreak | Occupational Health | Community Medicine
SM Journal of Public Health & Epidemiology is an open access peer reviewed journal publishing articles focused on Biostatistics, Environmental Health, Epidemiology, Genetics and Complex Dise...Readmore
ISSN: 2473-0661 Archive Submit a Manuscript Editors -
JSM Addiction Medicine and Therapy
Discipline | Clinical Medicine
Publisher, JSMCentralCocaine Addiction | Drug Addiction | Drug Rehabilitation
JSM Addiction Medicine and Therapy is an international, open access peer reviewed journal publishing high quality articles in the division of stress, self-control and addictive behaviors, causes...Readmore
Archive Submit a Manuscript Editors -

JSMC Clinical Oncology and Research
Discipline | Clinical Medicine
Publisher, JSMCentralGastrointestinal Cancers | Genitourinary Cancers | Sarcomas
JSMC Clinical Oncology and Research is an international, open access peer reviewed journal publishing high quality articles in the division of breast cancer, gastrointestinal cancers, genitourin...Readmore
Archive Submit a Manuscript Editors -

JSM Plant Biology and Research
Discipline | Life Sciences Group
Publisher, JSMCentralPlant Anatomy | Molecular Ecology and Evolution | Plant Biodiversity
JSM Plant Biology and Research is an international, open access peer reviewed journal publishing high quality articles in the division of plant physiology, plant molecular biology, plant biochem...Readmore
Archive Submit a Manuscript Editors -

JSM Clinical Cytology and Pathology
Discipline | Clinical Medicine
Publisher, JSMCentralCytochemical Staining Methods | Clinical Cytogenetics | Parasitology
JSM Clinical Cytology and Pathology is an international, open access peer reviewed journal publishing high quality articles in the division of FNA technique, Cytology Specimens cytochemical, Imm...Readmore
Archive Submit a Manuscript Editors -

JSM Vascular Medicine and Research
Discipline | Clinical Medicine
Publisher, JSMCentralVasospastic Disorders | Venous Diseases | Vascular Imaging
JSM Vascular Medicine and Research is an international, open access peer reviewed journal publishing high quality articles in the division of Abdominal Aortic Aneurysm, Arteriosclerosis, Blood C...Readmore
Archive Submit a Manuscript Editors -

Journal of Sexual Medicine and Reproductive Health
Discipline | Clinical Medicine
Publisher, JSMCentralErectile Dysfunction | Ejaculatory Disorders | Varicocele
Journal of Sexual Medicine and Reproductive Health is an international, open access peer reviewed journal publishing high quality articles in the division of Gender Identity, Sexual Dysfunctions...Readmore
Archive Submit a Manuscript Editors -

JSM Neurological Disorders and Stroke
Discipline | Clinical Medicine
Publisher, JSMCentralNeurogenetics | Neuromedicine | Neuroimmunology
IIF: 1.96
JSM Neurological Disorders and Stroke is an international, open access peer reviewed journal publishing high quality articles in the division of Neurology...Readmore
Archive Submit a Manuscript Editors -

JSM Pharmacology and Clinical Toxicology
Discipline | Life Sciences Group
Publisher, JSMCentralPharmaceutics | Cellular & Molecular Pharmacology | Clinical Toxicology
JSM Pharmacology and Clinical Toxicology is an international, open access peer reviewed journal publishing high quality articles in the division of pharmaceutics, cellular and molecular pharmaco...Readmore
Archive Submit a Manuscript Editors -

JSMC Nanotechnology and Nanomedicine
Discipline | Life Sciences Group
Publisher, JSMCentralNanosensors | Molecular Nanoscience | Convincible Medical Applications
JSMC Nanotechnology and Nanomedicine is an international, open access peer reviewed journal publishing high quality articles in the division of Advances in Nanotechnology, Nano engineering, Nano...Readmore
Archive Submit a Manuscript Editors -

JSM Pediatrics and Child Health
Discipline | Clinical Medicine
Publisher, JSMCentralHealth Promotion | Growth and Development | Palliative Care
JSM Pediatrics and Child Health is an international, open access peer reviewed journal publishing high quality articles in the division of Health promotion, Managing disease relating to growth a...Readmore
Archive Submit a Manuscript Editors -

JSM Obstetrics and Gynecology
Discipline | Clinical Medicine
Publisher, JSMCentralLow Risk Obstetric Care | Contraception | Menopause Management
JSM Obstetrics and Gynecology is an international, open access peer reviewed journal publishing high quality articles in the division of diagnostic, therapeutic procedures and treatments, routin...Readmore
Archive Submit a Manuscript Editors -

JSMC Hepatitis
Discipline | Clinical Medicine
Publisher, JSMCentralHepatitis Infection | Ischemic Hepatitis | Autoimmune Hepatitis
JSMC Hepatitis is an international, open access peer reviewed journal publishing high quality articles in the division covering basic research, molecular processes of hepatitis in...Readmore
Archive Submit a Manuscript Editors -

JSMC Clinical Case Reports
Discipline | Clinical Medicine
Publisher, JSMCentralClinical Pathology | Clinical Cardiology | Clinical Virology
JSMC Clinical Case Reports is an international, open access peer reviewed journal publishing high quality articles in the division of reviews and case reports in the clinical field on various ty...Readmore
Archive Submit a Manuscript Editors -

JSM Clinical Anesthesiology
Discipline | Clinical Medicine
Publisher, JSMCentralAnesthesia Drugs | Analgesics | Anesthesia Side Effects
JSM Clinical Anesthesiology is an international, open access peer reviewed journal publishing high quality articles in the division of Analgesics, Anesthesia, Hyposedation, Anesthetic Administra...Readmore
Archive Submit a Manuscript Editors -

SM Bioinformatics, Genomics and Proteomics
Discipline | Life Sciences Group
Publisher, JSMCentralPlasma proteomics | Serum Proteomics | Cancer Proteomics
SM Bioinformatics, Genomics and Proteomics is an international, open access peer reviewed journal publishing high quality articles in the division across all areas of life science, biology, and ...Readmore
Archive Submit a Manuscript Editors -

JSM Radiology and Radiation Therapy
Discipline | Clinical Medicine
Publisher, JSMCentralCancer Stem Cells | DNA Repair | Low-dose Radiation
JSM Radiology and Radiation Therapy is an international, open access peer reviewed journal publishing high quality articles in the division of cancer stem cells, DNA repair, low-dose radiation, ...Readmore
Archive Submit a Manuscript Editors -

JSM Family Medicine and Community Health
Discipline | Clinical Medicine
Publisher, JSMCentralHealth Care Delivery | Occupational Health | Family Health Management
JSM Family Medicine and Community Health is an international, open access peer reviewed journal publishing high quality articles in the division of epidemiology, public policy and public health,...Readmore
Archive Submit a Manuscript Editors -

JSM Urology and Research
Discipline | Clinical Medicine
Publisher, JSMCentralPediatric Urology | Urologic Oncology | Surgical Urology
JSM Urology and Research is an international, open access peer reviewed journal publishing high quality articles in the division of Pediatric Urology, Urologic Oncology, Surgical Urology, Renal ...Readmore
Archive Submit a Manuscript Editors -

JSM Nursing and Practice
Discipline | Clinical Medicine
Publisher, JSMCentralNursing Education | Development and Research | Operating Rooms
JSM Nursing and Practice is an international, open access peer reviewed journal publishing high quality articles in the division of Ambulatory Clinics, Apheresis, Burn Unit, Cancer Center, Criti...Readmore
Archive Submit a Manuscript Editors -

JSM Clinical Medicine
Discipline | Clinical Medicine
Publisher, JSMCentralImmunology | Infectious Diseases | Nephrology
JSM Clinical Medicine is an international, open access peer reviewed journal publishing high quality articles in the major divisions of Cardiovascular Medicine, Endocrinology and Meta...Readmore
Archive Submit a Manuscript Editors -

JSM Breast Cancer and Research
Discipline | Clinical Medicine
Publisher, JSMCentralBreast Cysts | Benign Fibrocystic Disease | Nipple & Breast Itchiness
JSM Breast Cancer and Research is an international, open access peer reviewed journal publishing high quality articles in the division of breast stem cells, breast development and breast cancer,...Readmore
Archive Submit a Manuscript Editors -

JSM Otolaryngology and Rhinology
Discipline | Clinical Medicine
Publisher, JSMCentralHearing Loss | Facial Paralysis | Tinnitus
JSM Otolaryngology and Rhinology is an international, open access peer reviewed journal publishing high quality articles in the division of Otology, Congenital deformities of the ear and tempora...Readmore
Archive Submit a Manuscript Editors -

JSMC Dentistry
Discipline | Clinical Medicine
Publisher, JSMCentralPediatric Dentistry | Oral Surgery | Preventive Care
JSMC Dentistry is an international, open access peer reviewed journal publishing high quality articles in the division of General Dentistry, Pediatric Dentistry, Oral Surgery, Preventive Care, P...Readmore
Archive Submit a Manuscript Editors -

Annals of Environmental Science and Ecology
Discipline | Life Sciences Group
Publisher, JSMCentralGlobal Change | Biodiversity | Ecosystems
Annals of Environmental Science and Ecology is an international, open access peer reviewed journal publishing high quality articles in the division of world-class research like areas of global c...Readmore
Archive Submit a Manuscript Editors -

JSM Liver and Clinical Research
Discipline | Clinical Medicine
Publisher, JSMCentralFatty Liver | Cirrhosis | Liver Cancer
JSM Liver and Clinical Research is an international, open access, peer reviewed journal publishing high quality articles in the major divisions of acute and chronic liver diseases, including hep...Readmore
Archive Submit a Manuscript Editors -

JSMC Cardiothoracic Surgery
Discipline | Clinical Medicine
Publisher, JSMCentralMyocardial Revascularization | Cardiac Valve Repair | Cardiac Devices
JSMC Cardiothoracic Surgery is an international, open access, peer reviewed journal publishing high quality articles in the major divisions of myocardial revascularization, cardiac valve repair ...Readmore
Archive Submit a Manuscript Editors -

JSM Dermatology and Clinical Research
Discipline | Clinical Medicine
Publisher, JSMCentralPediatric Dermatology | Teledermatology | Mohs Surgery
JSM Dermatology and Clinical Research is an international, open access peer reviewed journal publishing high quality articles in the division of Dermatopathology, Pediatric Dermatology, Telederm...Readmore
Archive Submit a Manuscript Editors -

JSM Veterinary Medicine and Research
Discipline | Clinical Medicine
Publisher, JSMCentralVeterinary Microbiology | Animal Nutrition | Infectious Diseases
JSM Veterinary Medicine and Research is an international, open access peer reviewed journal publishing high quality articles in the division of all aspects of care, husbandry and management of t...Readmore
Archive Submit a Manuscript Editors -

JSM Endocrinology, Diabetes and Obesity
Discipline | Clinical Medicine
Publisher, JSMCentralThyroid Disorders | Lipid Disorders | Tumors
JSM Endocrinology, Diabetes and Obesity is an international, open access peer reviewed journal publishing high quality articles in the division of diabetes, hyperlipidemia and osteoporosis, thyr...Readmore
Archive Submit a Manuscript Editors -

JSM Clinical Pathology
Discipline | Life Sciences Group
Publisher, JSMCentralHematopathology | Cytogenetics | Transfusion Medicine
JSM Clinical Pathology is an international, open access peer reviewed journal publishing high quality articles in the division of clinical chemistry, Hematopathology, Transfusion medicine, Clini...Readmore
Archive Submit a Manuscript Editors -

JSM Orthopedics and Rheumatology
Discipline | Clinical Medicine
Publisher, JSMCentralSpine Surgery | Orthopedic Trauma | Infective Arthritis
JSM Orthopedics and Rheumatology is an international, open access peer reviewed journal publishing high quality articles in the division of Total joint reconstruction (arthroplasty), Pediatric o...Readmore
Archive Submit a Manuscript Editors -
JSMC Microbiology
Discipline | Life Sciences Group
Publisher, JSMCentralApplied Microbiology | Antimicrobials | Microbial Enzymes
JSMC Microbiology is an international, open access peer reviewed journal publishing high quality articles in the division Cellular microbiology, Applied Microbiology, Antimicrobials, Microbe-Hos...Readmore
Archive Submit a Manuscript Editors -

JSM Human Nutrition and Food Science
Discipline | Life Sciences Group
Publisher, JSMCentralDiabetes Nutrition | Food Engineering | Nutrigenomics
JSM Human Nutrition and Food Science is an international, open access peer reviewed journal publishing high quality articles in the division of Food Processing, Diabetes Nutrition, Food Engineer...Readmore
Archive Submit a Manuscript Editors -

JSM Surgery and Transplantation Science
Discipline | Clinical Medicine
Publisher, JSMCentralLiving Kidney Donation | Kidney | Bone Marrow
JSM Surgery and Transplantation Science is an international, open access peer reviewed journal publishing high quality articles in the division of liver transplantation, small bowel transplantat...Readmore
Archive Submit a Manuscript Editors -

JSM Sports Medicine and Research
Discipline | Clinical Medicine
Publisher, JSMCentralGeneral Sports | Sports Injuries | Exercise Physiology
JSM Sports Medicine and Research is an international, open access peer reviewed journal publishing high quality articles in the division of General sports, Sports injuries, Rehabilitation and In...Readmore
Archive Submit a Manuscript Editors -

JSM Aquaculture and Research
Discipline | Life Sciences Group
Publisher, JSMCentralAquaculture Production | Fisheries | Food Processing
JSM Aquaculture and Research is an international, open access peer reviewed journal publishing high quality articles in the division of Aquaculture Industry, Fisheries, Aquaculture Nutrition, Aq...Readmore
Archive Submit a Manuscript Editors -

JSM Musculoskeletal Disorders
Discipline | Clinical Medicine
Publisher, JSMCentralBaker's Cyst | Bursitis | Degenerative Disk Disease
JSM Musculoskeletal Disorders is an international, open access peer reviewed journal publishing high quality articles in the division covering injuries and disorders that affect the hu...Readmore
Archive Submit a Manuscript Editors -

JSMC Biochemistry and Molecular Research
Discipline | Life Sciences Group
Publisher, JSMCentralNutritional Biochemistry | Physical Biochemistry | DNA Repair
JSMC Biochemistry and Molecular Research is an international, open access peer reviewed journal publishing high quality articles in the division of analysis of structure and function of complex ...Readmore
Archive Submit a Manuscript Editors -

JSM Analytical and Bioanalytical Techniques
Discipline | Life Sciences Group
Publisher, JSMCentralBioanalytical Chemistry | Instrumentation Methods | Analytical Chemistry
JSM Analytical and Bioanalytical Techniques is an international, open access peer reviewed journal publishing high quality articles in the major divisions of analytical and bioanalytical chemist...Readmore
Archive Submit a Manuscript Editors -

Annals of Burns and Trauma
Discipline | Clinical Medicine
Publisher, JSMCentralBurns | Trauma | Sepsis
Annals of Burns and Trauma Journal is an international, open access peer reviewed journal publishing high quality articles in the contributions to cutting edge, multidisciplinary approach that b...Readmore
Archive Submit a Manuscript Editors -

International Journal of Fisheries Science and Research
Discipline | Life Sciences Group
Publisher, JSMCentralFisheries | Fish Harvesting | Pisciculture
International Journal of Fisheries Science and Research is an open access peer reviewed journal publishing articles on species fisheries worldwide for finfish, mollusks, crustaceans and echinode...Readmore
Archive Submit a Manuscript Editors -

Journal of General Medicine
Discipline | Clinical Medicine
Publisher, JSMCentralInternal Medicine | Primary Care | Healthcare Education
Journal of General Medicine is an open access peer reviewed journal publishing articles in areas of patient care, research, education and training. Our experienced team of experts provides edito...Readmore
Archive Submit a Manuscript Editors -

Journal of Radiation Oncology & Research
Discipline | Clinical Medicine
Publisher, JSMCentralRadiology | Oncology | Radiotherapy
Journal of Radiation Oncology & Researchis an open access peer reviewed journal publishing articles covering the most state-of-the-art imaging systems and radiation delivery platforms, radia...Readmore
Archive Submit a Manuscript Editors -

Journal of Surgical Oncology & Clinical Research
Discipline | Clinical Medicine
Publisher, JSMCentralSurgery | Cancer Surgery | Postoperative Pain Management
Journal of Surgical Oncology & Clinical Researchis an open access peer reviewed journal publishing articles those provide cutting-edge surgical care for cancer patients with cancers involvin...Readmore
Archive Submit a Manuscript Editors -

SM Addiction Research & Therapy
Discipline | Clinical Medicine
Publisher, JSMCentralAddiction | Substance Abuse | Rehabiliation
SM Addiction Research & Therapy journalis an open access peer reviewed journal publishing articles those provide information on daily challenges associated with overcoming various addictions...Readmore
Archive Submit a Manuscript Editors -

SM Journal of Anesthesia
Discipline | Clinical Medicine
Publisher, JSMCentralAnesthesia Procedures | Pain Management | Anesthetics
SM Journal of Anesthesia is an open access peer reviewed journal publishing articles focused in variety of clinical subspecialties including critical care medicine, pediatrics, congenital heart ...Readmore
Archive Submit a Manuscript Editors -

SM Journal of Cardiology and Cardiovascular Diseases
Discipline | Clinical Medicine
Publisher, JSMCentralInterventional Cardiology | Arrhythmia | Cardiothoracic Surgery
SM Journal of Cardiology and Cardiovascular Diseases is an open access peer reviewed journal publishing articles focused on cardiovascular medicine, interventional cardiology, transplant cardiol...Readmore
Archive Submit a Manuscript Editors -

SM Journal of Clinical and Medical Imaging
Discipline | Clinical Medicine
Publisher, JSMCentralRadiology | Imaging | Imaging Technologies
SM Journal of Clinical and Medical Imaging is an open access peer reviewed journal publishing articles focused on research in image modalities such as CT, X-Rays (radiography), fluoroscopy, mamm...Readmore
Archive Submit a Manuscript Editors -

SM Journal of Clinical Pathology
Discipline | Clinical Medicine
Publisher, JSMCentralCytology | Histology | Tissue Analysis
SM Journal of Clinical Pathology is an open access peer reviewed journal publishing articles that spurs your interest in knowing more about our unique and progressive in key functional areas of ...Readmore
Archive Submit a Manuscript Editors -

SM Journal of Endocrinology and Metabolism
Discipline | Clinical Medicine
Publisher, JSMCentralDiabetes | Hormone Imbalance | Metabolic Disorders
SM Journal of Endocrinology and Metabolism is an open access peer reviewed journal publishing articles that focus on diagnosis, treatment and research of diabetes and other endocrine & metab...Readmore
Archive Submit a Manuscript Editors -

SM Journal of Environmental Toxicology
Discipline | Life Sciences Group
Publisher, JSMCentralChemical Engineering | Toxic Substances | Environmental Pollution
SM Journal of Environmental Toxicology is an open access peer reviewed journal publishing articles that focus on various aspects including Ecotoxicology, Fundamentals Environmental Engineering, ...Readmore
Archive Submit a Manuscript Editors -

SM Journal of Family Medicine
Discipline | Clinical Medicine
Publisher, JSMCentralFamily Planning | Family Healthcare | Family Physicians
SM Journal of Family Medicine is an open access peer reviewed journal publishing articles that focus on various aspects covering but not limiting to complete medical care for all patients, regar...Readmore
Archive Submit a Manuscript Editors -

SM Journal of Gastroenterology & Hepatology
Discipline | Clinical Medicine
Publisher, JSMCentralGastric Cancer | IBD | GERD
SM Journal of Gastroenterology & Hepatology is an open access peer reviewed journal publishing articles that focus on disciplines covering diseases of digestive tract (esophagus, stomach, sm...Readmore
Archive Submit a Manuscript Editors -

SM Journal of Hematology & Oncology
Discipline | Clinical Medicine
Publisher, JSMCentralHematological Cancers | Transfusion Medicine | Blood Analysis
SM Journal of Hematology & Oncology is an open access peer reviewed journal publishing articles that focus on key functional areas such as hematology, chemoprevention, cell signal pathways, ...Readmore
Archive Submit a Manuscript Editors -

SM Journal of Minimally Invasive Surgery
Discipline | Clinical Medicine
Publisher, JSMCentralLaparoscopy | Surgical Outcomes | Keyhole Surgery
SM Journal of Minimally Invasive Surgery is an open access peer reviewed journal publishing articles those focus on minimally invasive surgeries those associated with less pain, a shorter hospit...Readmore
Archive Submit a Manuscript Editors -

SM Journal of Nanotechnology and Nanomedicine
Discipline | Life Sciences Group
Publisher, JSMCentralNanomaterials | Targetted Therapies | Medical Applications
SM Journal of Nanotechnology and Nanomedicine is an open access peer reviewed journal publishing articles those focus on properties, applications, toxicity and preparation methods of thousands o...Readmore
Archive Submit a Manuscript Editors -

SM Journal of Neurological Disorders and Stroke
Discipline | Clinical Medicine
Publisher, JSMCentralBrain Disorders | Cerebral Aneurysms | Neurosurgeries
SM Journal of Neurological Disorders and Stroke is an open access peer reviewed journal publishing articles providing information on epilepsy, stroke, movement disorders, memory disorders and de...Readmore
Archive Submit a Manuscript Editors -

SM Journal of Pediatrics
Discipline | Clinical Medicine
Publisher, JSMCentralPediatric Surgeries | Pediatric Cancers | Pediatric Nutrition
SM Journal of Pediatrics is an open access peer reviewed journal publishing articles providing information on research, education and the clinical care of infants, children and young adults, etc...Readmore
Archive Submit a Manuscript Editors -

SM Journal of Radiology
Discipline | Clinical Medicine
Publisher, JSMCentralRadiation Oncology | Radiation Therapy | Imaging Techniques
SM Journal of Radiology is an open access peer reviewed journal publishing articles committed to provide significant information on interdisciplinary research efforts in anatomic imaging, instru...Readmore
Archive Submit a Manuscript Editors -

SM Journal of Reproductive Health & Infertility
Discipline | Clinical Medicine
Publisher, JSMCentralReproductive Health | Gynecological Problems | IVF
SM Journal of Reproductive Health & Infertility is an open access peer reviewed journal publishing articles committed to provide significant information on Family Planning, Gynecology, Gynec...Readmore
Archive Submit a Manuscript Editors -

SM Journal of Sarcoma Research
Discipline | Clinical Medicine
Publisher, JSMCentralSoft Tissue Sarcomas | Clinical Management | Bone Sarcomas
SM Journal of Sarcoma Research is an open access peer reviewed journal publishing articles committed to provide significant information on Sarcoma Immunotherapy, Improved drug delivery, new drug...Readmore
Archive Submit a Manuscript Editors -

SM Journal of Stem Cell Research
Discipline | Clinical Medicine
Publisher, JSMCentralCancer Stem Cells | Embryonic Stem Cells | Stem Cell Research
SM Journal of Stem Cell Research is an open access peer reviewed journal publishing articles committed to provide significant information on specific stem cells those able to replace damaged tis...Readmore
Archive Submit a Manuscript Editors -

SM Journal of Trauma Care & Treatment
Discipline | Clinical Medicine
Publisher, JSMCentralPsychological Trauma | Physical Injury | Complex Trauma
SM Journal of Trauma Care & Treatment is an open access peer reviewed journal publishing articles committed to provide significant information on comprehensive emergency care, including nece...Readmore
Archive Submit a Manuscript Editors -

SM Ophthalmology Journal
Discipline | Clinical Medicine
Publisher, JSMCentralEye Diseases | Eye Surgery | Vision Problems
SM Ophthalmology Journal is an open access peer reviewed journal publishing articles including areas of all subspecialties including but not limited to Cornea and refractive surgery, retina and ...Readmore
Archive Submit a Manuscript Editors -

SM Physical Medicine & Rehabilitation
Discipline | Clinical Medicine
Publisher, JSMCentralPhysical Activity | Physiatry | Rehabiliation
SM Physical Medicine & Rehabilitation journal is an open access peer reviewed journal publishing articles including areas of brain injury and stroke, spinal cord injury, acute and chronic pa...Readmore
Archive Submit a Manuscript Editors -

SM Sports Medicine & Therapy
Discipline | Clinical Medicine
Publisher, JSMCentralSports Injury | Athlete Healthcare | Exercise Medicine
SM Sports Medicine & Therapy journal is an open access peer reviewed journal publishing articles in state of the art surgical and non-surgical treatment options for musculoskeletal injuries ...Readmore
Archive Submit a Manuscript Editors -

SM Surgery Journal
Discipline | Clinical Medicine
Publisher, JSMCentralSurgical Outcome | Clinical Procedures | Advanced Surgical Techniques
SM Surgery Journal is an open access peer reviewed journal publishing articles providing information on finest surgical patient care, world-class research and offer state-of-the art education. O...Readmore
Archive Submit a Manuscript Editors -

SM Journal of Vaccine Research
Discipline | Life Sciences Group
Publisher, JSMCentralVaccine Development | Vaccination | Immunization
SM Journal of Vaccine Research is an open access peer reviewed journal publishing articles providing information on all vaccines and immunization for infants, children, teenagers, adults, and se...Readmore
Archive Submit a Manuscript Editors -

SM Vascular Medicine
Discipline | Clinical Medicine
Publisher, JSMCentralVascular Surgeries | Vascular Health | Vascular Aneurysms
SM Vascular Medicine journal is an open access peer reviewed journal publishing articles providing information on comprehensive care for diseases of the vascular system, peripheral artery diseas...Readmore
Archive Submit a Manuscript Editors -
SM Virology
Discipline | Life Sciences Group
Publisher, JSMCentralViral Invasions | Parasites | Viral Diseases
SM Virology journal is an open access peer reviewed journal publishing articles providing information on both basic and applied research, focusing on the molecular biology and immunology of seve...Readmore
Archive Submit a Manuscript Editors






























